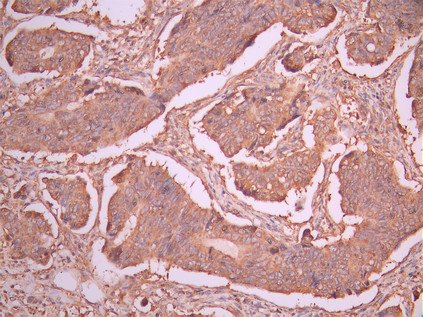

TDGF1 Recombinant Monoclonal Antibody
-
中文名稱:TDGF1 Recombinant Monoclonal Antibody
-
貨號:CSB-RA199069A0HU
-
規(guī)格:¥1320
-
圖片:
-
IHC image of CSB-RA199069A0HU diluted at 1:100 and staining in paraffin-embedded human kidney tissue performed on a Leica BondTM system. After dewaxing and hydration, antigen retrieval was mediated by high pressure in a citrate buffer (pH 6.0). Section was blocked with 10% normal goat serum 30min at RT. Then primary antibody (1% BSA) was incubated at 4°C overnight. The primary is detected by a Goat anti-rabbit polymer IgG labeled by HRP and visualized using 0.05% DAB.
-
IHC image of CSB-RA199069A0HU diluted at 1:100 and staining in paraffin-embedded human colorectal cancer performed on a Leica BondTM system. After dewaxing and hydration, antigen retrieval was mediated by high pressure in a citrate buffer (pH 6.0). Section was blocked with 10% normal goat serum 30min at RT. Then primary antibody (1% BSA) was incubated at 4°C overnight. The primary is detected by a Goat anti-rabbit polymer IgG labeled by HRP and visualized using 0.05% DAB.
-
-
其他:
產(chǎn)品詳情
-
Uniprot No.:
-
基因名:
-
別名:CR antibody; CRGF antibody; Cripto 1 antibody; Cripto 1 growth factor antibody; cripto antibody; Cripto-1 growth factor antibody; Cripto1 growth factor antibody; Epidermal growth factor like cripto protein CR1 antibody; Epidermal growth factor-like cripto protein CR1 antibody; TDGF 1 antibody; TDGF1 antibody; TDGF1_HUMAN antibody; Teratocarcinoma derived growth factor 1 antibody; Teratocarcinoma-derived growth factor 1 antibody
-
反應種屬:Human
-
免疫原:A synthesized peptide from human TDGF1 protein
-
免疫原種屬:Homo sapiens (Human)
-
標記方式:Non-conjugated
-
克隆類型:Monoclonal
-
抗體亞型:Rabbit IgG
-
純化方式:Affinity-chromatography
-
克隆號:14B11
-
濃度:It differs from different batches. Please contact us to confirm it.
-
保存緩沖液:Rabbit IgG in 10mM phosphate buffered saline , pH 7.4, 150mM sodium chloride, 0.05% BSA, 0.02% sodium azide and 50% glycerol.
-
產(chǎn)品提供形式:Liquid
-
應用范圍:ELISA, IHC
-
推薦稀釋比:
Application Recommended Dilution IHC 1:50-1:200 -
Protocols:
-
儲存條件:Upon receipt, store at -20°C or -80°C. Avoid repeated freeze.
-
貨期:Basically, we can dispatch the products out in 1-3 working days after receiving your orders. Delivery time maybe differs from different purchasing way or location, please kindly consult your local distributors for specific delivery time.
-
用途:For Research Use Only. Not for use in diagnostic or therapeutic procedures.
相關產(chǎn)品
靶點詳情
-
功能:GPI-anchored cell membrane protein involved in Nodal signaling. Cell-associated TDGF1 acts as a Nodal coreceptor in cis. Shedding of TDGF1 by TMEM8A modulates Nodal signaling by allowing soluble TDGF1 to act as a Nodal coreceptor on other cells. Could play a role in the determination of the epiblastic cells that subsequently give rise to the mesoderm.
-
基因功能參考文獻:
- Cripto-1 expression is increased by OCT4 overexpression, but decreased by shRNA-mediated OCT4 knockdown. OCT4 overexpression significantly activates Cripto-1 transcriptional activity. A 5'-upstream minimal promoter sequence in the gene-encoding Cripto-1 is significantly activated by OCT4 overexpression. PMID: 29223130
- Targeting the Cripto-1/TAK-1/NF-kappaB/Survivin pathway may be an effective approach to combat apoptosis resistance in cancer. PMID: 29807222
- Knockdown of Cripto-1 inhibits the proliferation, migration, invasion, and angiogenesis in prostate carcinoma cells. PMID: 29358554
- Results identified elevated CR-1 expression in esophageal squamous cell carcinoma (ESCC) specimens which correlated to poor prognosis of the patients. CR-1 high cells isolated from ESCC cells possess cancer stem-like cells (ECSLC) properties. PMID: 28431580
- These results highlight a functional role for CRIPTO and GRP78 in prostate cancer metastasis and suggest that targeting CRIPTO/GRP78 signaling may have significant therapeutic potential. PMID: 28394345
- PGAP6 plays a critical role in Nodal signaling modulation through CRIPTO shedding. PMID: 27881714
- Upregulation of cripto-1 is associated with prostate cancer. PMID: 28098905
- the miR-15b expression is negatively associated with the cripto-1 expression in glioma cells. miR-15b may subsequently impair growth and invasion of glioma cells through targeted regulation of cripto-1. PMID: 27082313
- These findings suggest that CRIPTO expression may be a useful serological marker for diagnostic and/or prognostic purposes during germ cell cancer management. PMID: 26654129
- serum CR-1 is a useful diagnostic and prognostic marker for nonsmall cell lung cancer patients. PMID: 26109366
- Cripto-1 overexpression contributes to aggressiveness and poor prognosis of hepatocellular carcinoma PMID: 26375669
- The main signaling pathways mediating Cripto-1 effects include Nodal-dependent (Smad2/3) and Nodal-independent (Src/p44/42/Akt) signaling transduction pathways PMID: 26327334
- Cripto-1 is a novel and dynamically regulated effector of stem cell functions in colorectal cancer. PMID: 26343543
- these findings suggest a novel molecular network, involving CRIPTO, AKT, and FGFR signaling, in favor of the emergence of mesenchymal-like cancer cells during the development of aggressive prostate tumors. PMID: 25596738
- Report lower gene expression of Cripto in endometriosis but difference not maintained at protein level. PMID: 25228630
- Treatment of U-87 MG cells with CR-1 leads to higher expression of drug efflux protein MDR-1 in the CR-1 positive subpopulation, indicating correlated induction of these two proteins. PMID: 25658584
- These findings clearly suggest that the downregulation of miR-15a-16 with Cripto amplification may be involved in the development of nonsmall cell lung cancer. PMID: 24500260
- Snail represses Cripto-1 gene by direct transcriptional interaction PMID: 25889638
- CR-1 expression in glioblastoma multiforme(GBM)tissue and blood; CR-1 plasma levels from GBM patients were elevated compared with normal; CR-1 concentrations higher than normal correlated with shorter overall survival; identified CR-1 in different areas of GBM tissue including perivascular tumor cells and endothelial cells PMID: 24521322
- the functional analysis of the main associated locus identified a causal variant in the 5'UTR of CRIPTO gene which is able to strongly modulate CRIPTO expression through an AP-1-mediate transcriptional regulation. PMID: 25629528
- Our findings suggest that high Cripto-1 expression might be involved in the development of bladder cancer and a potentially effective prognostic marker in bladder cancer patients PMID: 25326807
- Over expression of Cripto-1 was correlated with the occurrence, development, metastasis and malignant degree of lung adenocarcinoma. PMID: 25796148
- these findings identify the CRIPTO/GRP78 pathway as a developmentally conserved regulator of fetal and adult mammary stem cell behavior ex vivo, with implications for the stem-like cells found in many cancers. PMID: 24749068
- This study demonstrated CR-1 expression in the placental bed, its increased expression in creta placentas, and EVT cells as the main CR-1-producing cell type. PMID: 25165718
- Data suggest that the high expression of Cripto-1 (CR-1) may play an important role in the progression of non-small cell lung cancer (NSCLC), and CR-1 expression may offer a valuable marker for predicting the outcome of patients with NSCLC. PMID: 24870591
- Tumors from NSCLC patients with EGFR-activating mutations that were intrinsically resistant to EGFR-TKIs expressed higher levels of CRIPTO1 compared with tumors from patients that were sensitive to EGFR-TKIs. PMID: 24911146
- Cripto is overexpressed in colonic neoplasms and is related to cancer cell migration/invasion. PMID: 24379580
- The significance of cell surface CR-1 expression in human melanoma cells, was examined. PMID: 23574716
- Cross-talk between Cripto-1 and the Wnt/beta-catenin signaling pathway might play a role in mammary transformation leading to a more aggressive behavior of mammary cancer cells. PMID: 23022962
- Offer some insight into the transcriptional regulation of CR-1 gene expression and its critical role in the pathogenesis of human cancer. PMID: 23129342
- human testicular tumors showed upregulation of NODAL and CRIPTO that was proportional to invasiveness and to the number of malignant cells. PMID: 23034635
- Cripto/GRP78 modulates the TGF-beta pathway in development and oncogenesis [review] PMID: 22306319
- Cripto-1 may play a role during developmental EMT, and it may also be involved in the reprogramming of differentiated tumor cells into cancer stem cells through the induction of an EMT program. PMID: 22542493
- Cripto-1 plays a role in the malignant transformation of oral mucosa and is involved in the tumorigenesis and progression of oral squamous cell carcinoma by promoting the growth and migration of malignant cells. PMID: 21824804
- High CRIPTO-1 is associated with cutaneous melanoma. PMID: 21863025
- Disturbed expression of endometrial activin A, cripto , and follistatin suggests a dysfunction of the activin pathway in endometriosis/endometrioma. PMID: 21496809
- work firstly provides human genetic evidence of TDGF1 involved in the pathogenesis of ventricular septal defects PMID: 19853938
- expression of CR-1 may alter the physiochemical properties of the plasma membrane resulting in an enhancement of intercellular transfer of cellular signaling components which may account for the paracrine activity of CR-1. PMID: 21055389
- Results demonstrate that CR-1 expression is enriched in an undifferentiated, tumorigenic subpopulation and is regulated by key regulators of pluripotent stem cells. PMID: 20549704
- molecular model of activin receptor-like kinase 4/Cripto/Nodal complex built by homology modeling as well as docking tests aimed at identifying potential binding epitopes PMID: 20629020
- TDGF1 has a role in metachronous metastasis of colorectal cancer PMID: 20126975
- TDGF-1, which is significantly upregulated in APA and mediates aldosterone hypersecretion and deregulated growth in adrenocortical cells in vitro, may represent a key player in the development and pathophysiology of primary aldosteronism. PMID: 20385969
- Nodal and Cripto immunoreactivity increased dramatically in the transition from histologic Grade 1 to histologic Grades 2 and 3 endometrial carcinomas. PMID: 19874624
- Cripto has dual roles as a coreceptor as well as a coligand for Nodal and that this signaling interaction with Nodal is regulated by an unusual form of glycosylation. PMID: 12052855
- A loss-of-function mutation in the CFC domain of TDGF1 is associated with human forebrain defects. PMID: 12073012
- complexation with activin and type II activin receptors and role in blocking activin signaling PMID: 12682303
- CRIPTO signaling promotes cardiomyogenesis and redirects the neural fate of embryonic stem cells. PMID: 14581455
- Results suggest that cripto-1 overexpression might be associated with the progression towards a more aggressive phenotype in breast carcinoma, through the activation of both Akt and Smad-2 signalling pathways. PMID: 14584041
- The regulation of Netrin-1 expression is important in regulating Cripto-1-dependent invasion and migration of mammary epithelial cells. PMID: 16176936
- The plasma CR-1 might represent a novel biomarker for the detection of breast and colon carcinomas. A statistically significant increase in the levels of plasma CR-1 was found in patients with colon carcinoma and in patients with breast carcinoma. PMID: 16951234
顯示更多
收起更多
-
亞細胞定位:Cell membrane; Lipid-anchor, GPI-anchor. Secreted.
-
蛋白家族:EGF-CFC (Cripto-1/FRL1/Cryptic) family
-
組織特異性:Preferentially expressed in gastric and colorectal carcinomas than in their normal counterparts. Expressed in breast and lung.
-
數(shù)據(jù)庫鏈接:
Most popular with customers
-
-
Phospho-YAP1 (S127) Recombinant Monoclonal Antibody
Applications: ELISA, WB, IHC
Species Reactivity: Human
-
-
-
-
-
-